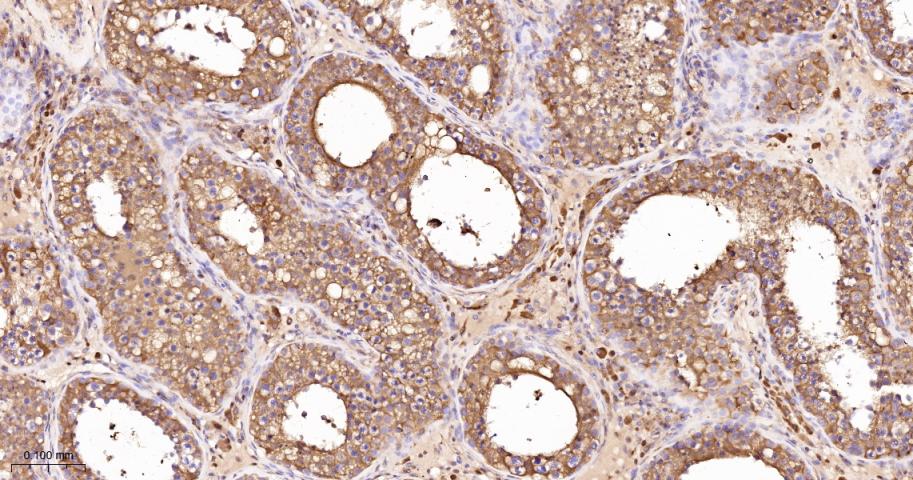
LDHA Rabbit pAb(bs-34202R)-50u

相关产品推荐更多 >

TREM1 Rabbit pAb, BF750 conjugated(bs-4886R-BF750)-100ul
¥2980
FMNL3 Rabbit pAb, Cy3 conjugated(bs-16151R-Cy3)-100ul
¥2980
HGFA Inhibitor 2 Rabbit pAb, BF350 conjugated(bs-10062R-BF350)-100ul
¥2980
TBX1 Rabbit pAb(bs-8257R)-50ul/100ul/200ul
¥1180
Anti-human TNFSF14 / LIGHT / CD258 (SAR252067 Biosimilar)(BIO0811SM)-1mg/5mg/20mg
¥3200
万千商家帮你免费找货
0 人在求购买到急需产品
- 详细信息
- 文献和实验
- 技术资料
- 应用范围:
产品信息以Bioss网站为准
- 规格:
50ul/100ul
| 规格: | 50ul | 产品价格: | ¥1180.0 |
|---|---|---|---|
| 规格: | 100ul | 产品价格: | ¥1980.0 |
| 产品编号 | bs-34202R |
| 英文名称 | LDHA Rabbit pAb |
| 中文名称 | 乳酸脱氢酶抗体 |
| 英文别名 | Lactate Dehydrogenase; Lactate Dehydrogenase Isoenzyme V; Lactate Dehydrogenase isozyme H4; L lactate dehydrogenase A chain; Lactate dehydrogenase A; Lactate dehydrogenase A chain; LDH A; LDH heart subunit; LDH M; LDHM; LDH muscle subunit; LDH1; LDHA; PIG 19; PIG19; Proliferation inducing gene 19 protein; TRG 5; TRG5; LDHA_HUMAN. |
| 产品应用 | WB=1:500-2000, IHC-P=1:100-500, IHC-F=1:100-500, IF=1:100-500 Not yet tested in other applications. |
| 交叉反应 | Human, Mouse, Rat |
| 抗体来源 | Rabbit |
| 免疫原 | KLH conjugated synthetic peptide derived from human LDHA |
| 亚型 | IgG |
| 性状 | Liquid |
| 纯化方法 | affinity purified by Protein A |
| 克隆类型 | Polyclonal |
| 理论分子量 | 37 kDa |
| 浓度 | 1mg/ml |
| 储存液 | 0.01M TBS (pH7.4) with 1% BSA, 0.02% Proclin300 and 50% Glycerol. |
| 研究领域 | Cancer > Cancer Metabolism > Metabolic signaling pathway > Metabolism of carbohydrates Kits/ Lysates/ Other > Kits > Cell Metabolism Kits > Dehydrogenase Kits Kits/ Lysates/ Other > Kits > Cell Metabolism Kits > Oxidative Stress Assay Kits > NADP/NADPH Metabolism > Pathways and Processes > Metabolic signaling pathways > Carbohydrate metabolism Metabolism > Pathways and Processes > Metabolic signaling pathways > Energy transfer pathways > Energy Metabolism Metabolism > Types of disease > Cancer Signal Transduction > Metabolism > Energy Metabolism |
| 亚基 | Homotetramer. |
| 亚细胞定位 | Cytoplasm. |
| 翻译后修饰 | ISGylated. |
| 相似性 | Belongs to the LDH/MDH superfamily. LDH family. |
| 保存条件 | Shipped at 4℃. Store at -20℃ for one year. Avoid repeated freeze/thaw cycles. |
| 注意事项 | This product as supplied is intended for research use only, not for use in human, therapeutic or diagnostic applications. |
| 背景资料 | The protein encoded by this gene catalyzes the conversion of L-lactate and NAD to pyruvate and NADH in the final step of anaerobic glycolysis. The protein is found predominantly in muscle tissue and belongs to the lactate dehydrogenase family. Mutations in this gene have been linked to exertional myoglobinuria. Multiple transcript variants encoding different isoforms have been found for this gene. The human genome contains several non-transcribed pseudogenes of this gene. [provided by RefSeq]. |
| 应用 | 推荐稀释比例 |
| {WB} | {1:500-2000} |
| {IHC-P} | {1:100-500} |
| {IHC-F} | {1:100-500} |
| {IF} | {1:100-500} |

风险提示:丁香通仅作为第三方平台,为商家信息发布提供平台空间。用户咨询产品时请注意保护个人信息及财产安全,合理判断,谨慎选购商品,商家和用户对交易行为负责。对于医疗器械类产品,请先查证核实企业经营资质和医疗器械产品注册证情况。
 文献和实验
文献和实验[IF={{ 6 }}] {Chang Zhibo. et al. NCAPD3 contributes to lung cancer progression through modulated lactate-induced histone lactylation and MEK/ERK/LDHA axis. CANCER CELL INT. 2025 Dec;25(1):1-13} {WB,IHC} {Mouse,Human}
[IF={{ 5.6 }}] {Hu Yile. et al. L-arginine combination with 5-fluorouracil inhibit hepatocellular carcinoma cells through suppressing iNOS/NO/AKT-mediated glycolysis. FRONT PHARMACOL. 2024 May;15:} {WB} {Rat,Human}
[IF={{ 2.2 }}] {Danhong Li. et al. N6-methyladenosine methyltransferase METTL3 facilitates the aerobic glycolysis of non-small cell lung cancer cells by activating the PI3K/AKT/mTOR pathway. BIOCHEM BIOPH RES CO. 2025 Jul;:152337} {WB} {Human}
[IF={{ 0 }}] {Zongwang Zhang. et al. AARS2 ameliorates myocardial ischemia via fine-tuning PKM2-mediated metabolism. ELIFE. 2025 五月 15} {WB} {Mouse,Rat}
 技术资料
技术资料暂无技术资料 索取技术资料





